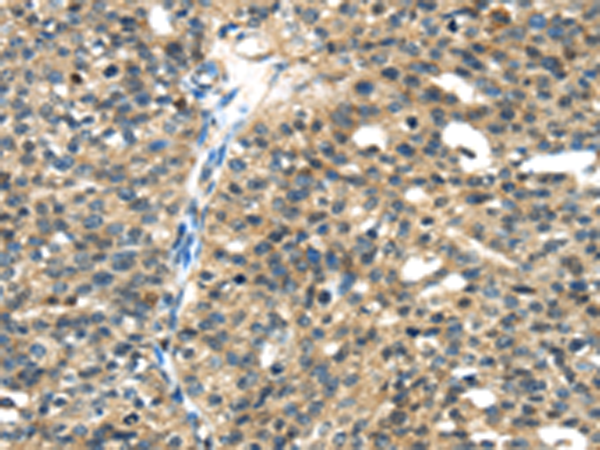

-
分类: 科研抗体货号: P08887别名: ECRG1应用: IHC反应种属: Human
-
分类: 科研抗体货号: P08886别名: DESC1; TMPRSS11E2应用: IHC反应种属: Human
-
分类: 科研抗体货号: P08902别名: EG1; magicin; 1500003D12Rik应用: WB,IHC反应种属: Human, Mouse, Rat
-
分类: 科研抗体货号: P08885别名: MSP; MSPL; MSPS; TMPRSS11应用: IHC反应种属: Human, Mouse
-
分类: 科研抗体货号: P08891别名: A20; AISBL; OTUD7C; TNFA1P2应用: IHC反应种属: Human, Mouse
-
分类: 科研抗体货号: P08901别名: TK; TKT1; HEL107应用: IHC反应种属: Human, Mouse, Rat
-
分类: 科研抗体货号: P08884别名: SPINESIN应用: WB,IHC反应种属: Human, Mouse
-
分类: 科研抗体货号: P08890别名: B94; EXOC3L3应用: IHC反应种属: Human
-
分类: 科研抗体货号: P08900别名: TGX; PSS2; TGM6; TGMX; TGASE5; TGASEX应用: WB,IHC反应种属: Human, Mouse
-
分类: 科研抗体货号: P08882别名: AROS-29应用: IHC反应种属: Human, Mouse

鄂公网安备42018502007531号
鄂公网安备42018502007531号

